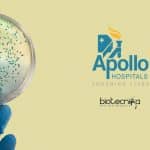
Apollo Hospitals Bengaluru Lab Technician – Microbiology Vacancy Apollo Hospitals Bengaluru Lab

Home Search
biology - search results
If you're not happy with the results, please do another search
Govt DBT India CIAB Recruitment For Biotech / Biochem & Microbiology
CIAB Research Jobs For Biotech / Biochem & Microbiology
CIAB Research Jobs For Biotech / Biochem & Microbiology. Center of Innovative and Applied Bioprocessing (CIAB)...
Thermo Fisher Scientific Protein Biology Scientist Recruitment
Thermo Fisher Scientific Protein Biology Scientist Recruitment
Thermo Fisher Scientific Protein Biology Scientist Recruitment. Thermo Fisher Scientific hiring for a Scientist II, Protein Biology job...
VIT Vellore Computational Biology Research Job With Rs. 47,000 pm Pay
VIT Vellore Computational Biology Research Job With Rs. 47,000 pm Pay
VIT Vellore Computational Biology Research Job With Rs. 47,000 pm Pay. PhD Candidates with...
CSIR Jobs For Biotech / Biochem & Microbiology at IICB
CSIR Jobs For Biotech / Biochem & Microbiology at IICB
CSIR Jobs For Biotech / Biochem & Microbiology at IICB. MSc Biotech, Biochem & Microbiology...
Apollo Hospitals Bengaluru Lab Technician – Microbiology Vacancy
Apollo Hospitals Bengaluru Lab Technician - Microbiology Vacancy
Apollo Hospitals Bengaluru Lab Technician - Microbiology Vacancy. Apollo Hospitals is hiring candidates for a Lab Technician...
CSIR-Indian Institute of Chemical Biology Research Fellow Recruitment
CSIR-IICB JRF Vacancy For Biochem, Molecular Biology & Microbiology
CSIR-IICB JRF Vacancy For Biochem, Molecular Biology & Microbiology. MSc Microbiology/ Molecular Biology & Biochemistry jobs...
MACS ARI Pune JRF Job – Biotech / Botany & Microbiology Apply
MACS ARI Pune JRF Job - Biotech / Botany & Microbiology Apply
MACS ARI Pune JRF Job - Biotech / Botany & Microbiology Apply. MSc...
Cancer Biology Research Fellow Recruitment at Panjab University
Cancer Biology Research Fellow Recruitment at Panjab University
Cancer Biology Research Fellow Recruitment at Panjab University. Candidates with Biochemistry/Microbiology/Biotechnology/Life Science qualification can apply for this vacancy...
AIIMS Delhi Microbiology & Life Science Research Fellow Vacancy
AIIMS Delhi Microbiology & Life Science Research Fellow Vacancy
AIIMS Delhi Microbiology & Life Science Research Fellow Vacancy. Senior Research Fellow Job for Microbiology/Life Sciences...
Govt RGCB Project Assistant Recruitment For Immunology/ Microbiology & Biotech
Govt RGCB Project Assistant Job For Immunology/ Microbiology & Biotech
Govt RGCB Project Assistant Job For Immunology/ Microbiology & Biotech. RGCB, Thiruvananthapuram is hiring MSc...
DIAGEO Careers – Biotech / Food Tech / Microbiology & Biochem Quality Executive Job
DIAGEO Careers - Biotech / Food Tech / Microbio & Biochem Quality Job
DIAGEO Careers - Biotech / Food Tech / Microbio & Biochem Quality...
MAHE Associate Jobs – Virology / Biotech & Microbiology Apply
MAHE Associate Jobs - Virology / Biotech & Microbiology Apply
MAHE Associate Jobs - Virology / Biotech & Microbiology Apply. MSc/PhD candidates with a background...
IISER Kolkata Biology & Zoology MoEFCC Funded Project Assistant Recruitment
IISER Kolkata Biology & Zoology Project Assistant Recruitment
IISER Kolkata Biology & Zoology Project Assistant Recruitment. MSc Biology & Zoology applicants are eligible to apply...
CSIR-CSMCRI Project Associate Job For Microbiology & Biotech
CSMCRI Associate Job For Biotech & Microbiology - Apply Online
CSMCRI Associate Job For Biotech & Microbiology - Apply Online. MSc Biotechnology, and Microbiology Project...
Govt DRDO-DRL Biotech & Microbiology Junior Research Fellow Recruitment
Govt DRDO-DRL Biotech & Microbiology Junior Research Fellow Recruitment
Govt DRDO-DRL Biotech & Microbiology Junior Research Fellow Recruitment. DRDO-DRL requires Microbiology/ Biotechnology candidates to apply...